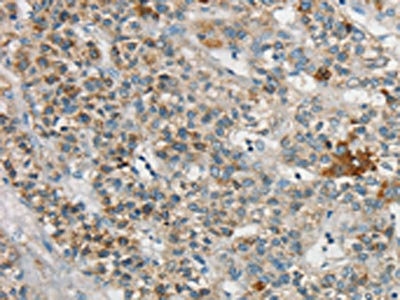

SYCP3 Antibody
-
中文名稱:SYCP3兔多克隆抗體
-
貨號:CSB-PA729972
-
規格:¥1100
-
圖片:
-
The image on the left is immunohistochemistry of paraffin-embedded Human liver cancer tissue using CSB-PA729972(SYCP3 Antibody) at dilution 1/20, on the right is treated with synthetic peptide. (Original magnification: ×200)
-
Gel: 12%SDS-PAGE, Lysate: 40 μg, Lane 1-4: Human testis tissue, Human seminoma tissue, Jurkat cells, human liver cancer tissue, Primary antibody: CSB-PA729972(SYCP3 Antibody) at dilution 1/200, Secondary antibody: Goat anti rabbit IgG at 1/8000 dilution, Exposure time: 40 seconds
-
-
其他:
產品詳情
-
Uniprot No.:
-
基因名:
-
別名:choline phosphotransferase 1 antibody; chpt1 antibody; COR 1 antibody; COR1 antibody; MGC71888 antibody; RNASCP3 antibody; SCP 3 antibody; SCP-3 antibody; SCP3 antibody; SPGF4 antibody; Sycp 3 antibody; Sycp3 antibody; SYCP3_HUMAN antibody; Synaptonemal complex protein 3 antibody
-
宿主:Rabbit
-
反應種屬:Human,Mouse,Rat
-
免疫原:Synthetic peptide of Human SYCP3
-
免疫原種屬:Homo sapiens (Human)
-
標記方式:Non-conjugated
-
抗體亞型:IgG
-
純化方式:Antigen affinity purification
-
濃度:It differs from different batches. Please contact us to confirm it.
-
保存緩沖液:-20°C, pH7.4 PBS, 0.05% NaN3, 40% Glycerol
-
產品提供形式:Liquid
-
應用范圍:ELISA,WB,IHC
-
推薦稀釋比:
Application Recommended Dilution ELISA 1:2000-1:5000 WB 1:500-1:2000 IHC 1:25-1:100 -
Protocols:
-
儲存條件:Upon receipt, store at -20°C or -80°C. Avoid repeated freeze.
-
貨期:Basically, we can dispatch the products out in 1-3 working days after receiving your orders. Delivery time maybe differs from different purchasing way or location, please kindly consult your local distributors for specific delivery time.
-
用途:For Research Use Only. Not for use in diagnostic or therapeutic procedures.
相關產品
靶點詳情
-
功能:Component of the synaptonemal complexes (SCS), formed between homologous chromosomes during meiotic prophase. Required for centromere pairing during meiosis in male germ cells. Required for normal meiosis during spermatogenesis and male fertility. Plays a lesser role in female fertility. Required for efficient phosphorylation of HORMAD1 and HORMAD2.
-
基因功能參考文獻:
- SCP3 is associated with lymphangiogenesis and provides insight into the SCP3-VEGF-C/VEGF-D axis based cancer therapy strategy. PMID: 28623914
- In the model, the reported compaction of chromosomal DNA caused by SYCP3 would result from its ability to bridge distant sites on a DNA molecule with the DNA-binding domains located at each end of its strut-like structure. PMID: 28287952
- SYCP3 binds to RAD51 and attenuates RAD51 activity during meiosis. PMID: 28745000
- SYCP3 binding and assembly on meiotic chromosomes leads to their organisation into compact structures compatible with recombination and crossover formation PMID: 24950965
- The T657C polymorphism of the SYCP3 gene is possibly associated with recurrent pregnancy loss of unknown cause in human. PMID: 25059562
- SCP3 plays an important role in the progression of cervical cancer PMID: 24905095
- SYCP3 mutations are not associated with the genetic susceptibility for meiotic arrest in infertile male patients with nonobstructive azoospermia in the Turkish population PMID: 22670862
- screening for genetic variants in AURKB and SYCP3 among these patients with reproductive problems using Sanger sequencing. Only one apparently non-pathogenic deletion was found in SYCP3. PMID: 23100464
- Positive synaptonemal complex protein 3 expression is a portent of poor outcome and may be a potential biomarker in the early stages of the non-small cell lung cancer for survival. PMID: 23069255
- mutations in SYCP3 do not contribute significantly to risk for recurrent miscarriage through maternal meiotic nondisjunction. PMID: 22197129
- Expression of SYCP3 inhibits the homologous recombination (HR) pathway mediated by RAD51. PMID: 22116401
- The 657T>C mutation of SYCP3 may not be associated with recurrent miscarriage caused by aneuploidy. PMID: 21357605
- mutation analysis of SYCP3, DNMT3L and MSH4 in patients with maturation arrest of spermatogenesis and couples with recurrent miscarriages; heterozygous change, detected in a conserved functional domain of the SYCP3 gene, was absent in >200 controls PMID: 21126912
- X-linked lymphocyte-regulated protein pM1 (XMR), XLR, and SCP3 render tumor cells resistant to antitumor immunity PMID: 20395201
- We suggest that SYCP3 has an essential meiotic function in human spermatogenesis that is compromised by the mutant protein via dominant negative interference. PMID: 14643120
- In contrast to previously reported high frequency of SYCP3 mutations in patients with azoospermia, only polymorphisms are found in the present study PMID: 16213863
- SYCP3 is expressed in human testis and is restricted to germ cells. Lack of SYCP3 expression in human testis may have a negative effect on spermatogenesis and male fertility. PMID: 16824523
- No functional SYCP3 exonic SNP was found in infertile Spanish patients with meiosis arrest, suggesting that SYCP3 mutations very likely are not relevant in Spain in genetic susceptibility to meiosis arrest. PMID: 17434513
- These observations suggest that SCP3 is expressed in adult human and monkey ovaries. PMID: 18256545
- mutations in SYPR3 are likely to generate an aberrant synaptonemal complex in a dominant-negative manner and contribute to abnormal chromosomal behavior that might lead to recurrent miscarriage. PMID: 19110213
顯示更多
收起更多
-
相關疾病:Spermatogenic failure 4 (SPGF4); Pregnancy loss, recurrent, 4 (RPRGL4)
-
亞細胞定位:Nucleus. Chromosome. Chromosome, centromere.
-
蛋白家族:XLR/SYCP3 family
-
組織特異性:Testis-specific.
-
數據庫鏈接:
Most popular with customers
-
-
YWHAB Recombinant Monoclonal Antibody
Applications: ELISA, WB, IHC, IF, FC
Species Reactivity: Human, Mouse, Rat
-
Phospho-YAP1 (S127) Recombinant Monoclonal Antibody
Applications: ELISA, WB, IHC
Species Reactivity: Human
-
-
-
-
-